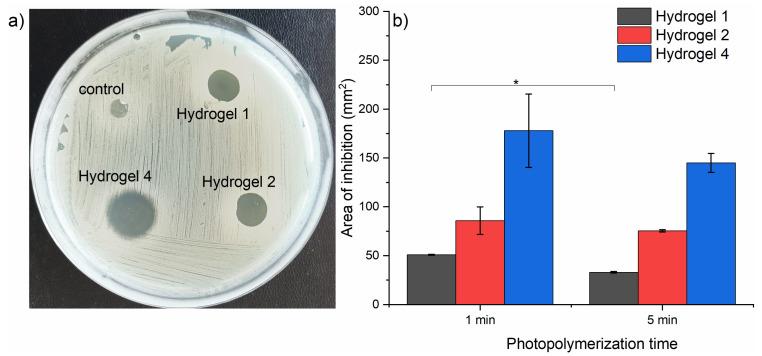

载氯丙嗪的甲基丙烯酰化明胶水凝胶的光聚合:表征及抗菌应用
Photopolymerization of Chlorpromazine-Loaded Gelatin Methacryloyl Hydrogels: Characterization and Antimicrobial Applications.
作者信息
Tozar Tatiana, Nistorescu Simona, Gradisteanu Pircalabioru Gratiela, Boni Mihai, Staicu Angela
机构信息
Laser Department, National Institute for Laser, Plasma and Radiation Physics, 409 Atomistilor, Magurele, 077125 Ilfov, Romania.
Department of Biochemistry and Molecular Biology, Faculty of Biology, University of Bucharest, 91-95 Splaiul Independentei, 050095 Bucharest, Romania.
出版信息
Gels. 2024 Sep 30;10(10):632. doi: 10.3390/gels10100632.
This study investigates the synthesis, characterization, and antimicrobial properties of hydrogels synthesized through the UV-pulsed laser photopolymerization of a polymer-photoinitiator-chlorpromazine mixture. Chlorpromazine was used for its known enhanced antimicrobial properties when exposed to UV laser radiation. The hydrogel was formed from a mixture containing 0.05% Irgacure 2959, 10% gelatin methacryloyl, and various concentrations of chlorpromazine (1, 2, and 4 mg/mL). Laser-induced fluorescence spectroscopy was employed to monitor the photoinduced changes of chlorpromazine and Irgacure 2959 during hydrogel formation, providing insight into the photodegradation dynamics. FTIR spectroscopy confirmed the incorporation of irradiated chlorpromazine within the hydrogel matrix, while the release profiles of chlorpromazine showed sustained release only in hydrogels containing 1 mg/mL of CPZ. The hydrogel showed significant antimicrobial activity against MRSA bacteria when compared to that of penicillin. These findings highlight the potential of CPZ loaded during the photopolymerization process into hydrogels as effective antimicrobial agents with sustained release properties, making them suitable for combating resistant bacterial strains.
本研究调查了通过聚合物 - 光引发剂 - 氯丙嗪混合物的紫外脉冲激光光聚合合成的水凝胶的合成、表征及抗菌性能。氯丙嗪因其在紫外激光辐射下已知的增强抗菌性能而被使用。水凝胶由含有0.05% 二苯甲酮、10% 甲基丙烯酰化明胶和不同浓度氯丙嗪(1、2和4 mg/mL)的混合物形成。采用激光诱导荧光光谱法监测水凝胶形成过程中氯丙嗪和二苯甲酮的光致变化,从而深入了解光降解动力学。傅里叶变换红外光谱证实了辐照后的氯丙嗪纳入水凝胶基质,而氯丙嗪的释放曲线显示仅在含有1 mg/mL氯丙嗪的水凝胶中有持续释放。与青霉素相比,该水凝胶对耐甲氧西林金黄色葡萄球菌显示出显著的抗菌活性。这些发现突出了在光聚合过程中负载到水凝胶中的氯丙嗪作为具有持续释放特性的有效抗菌剂的潜力,使其适用于对抗耐药菌株。